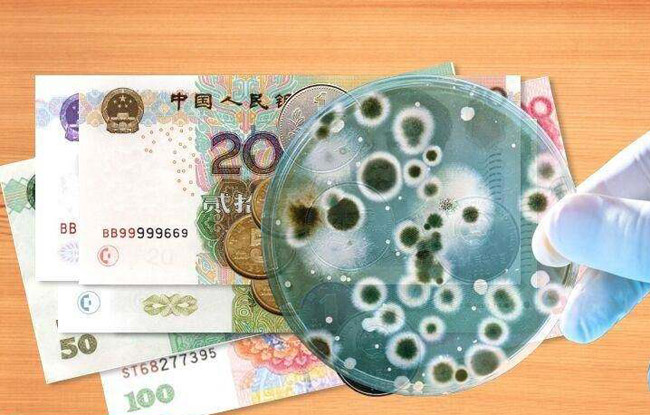

的确,现在土豪很多,但是要是以炫富的方式表达自己的心意,恐怕反而不能令人接受。还有网友表示:他还是一个刚出生的婴儿,还没有什么免疫力,200万泰铢堆在他身上,这得产生多少细菌,这会导致孩子皮肤过敏,甚至还会导致呼吸疾病,大人做事情也应该慎重考虑,毕竟孩子的健康才是最重要的。其实网友的担心还是非常有道理的,这么小的孩子,其实大人应该为他树立起榜样。我们也希望孩子能健康快乐地成长。
婴儿盖40万现金睡
其实我们很多人在别人过生日也好,结婚也好,送去的礼物也只有金钱,仿佛一切关系都被物化了。在对待朋友,对待亲人时,我们更应该用心,一份用心挑选或者制作的礼物,比随随便便给的现金或者卡珍贵的多。但往往很多人也亵渎了别人对他表达的真实情感,却把物质的东西放到第一位,这样也让人感到寒心。









